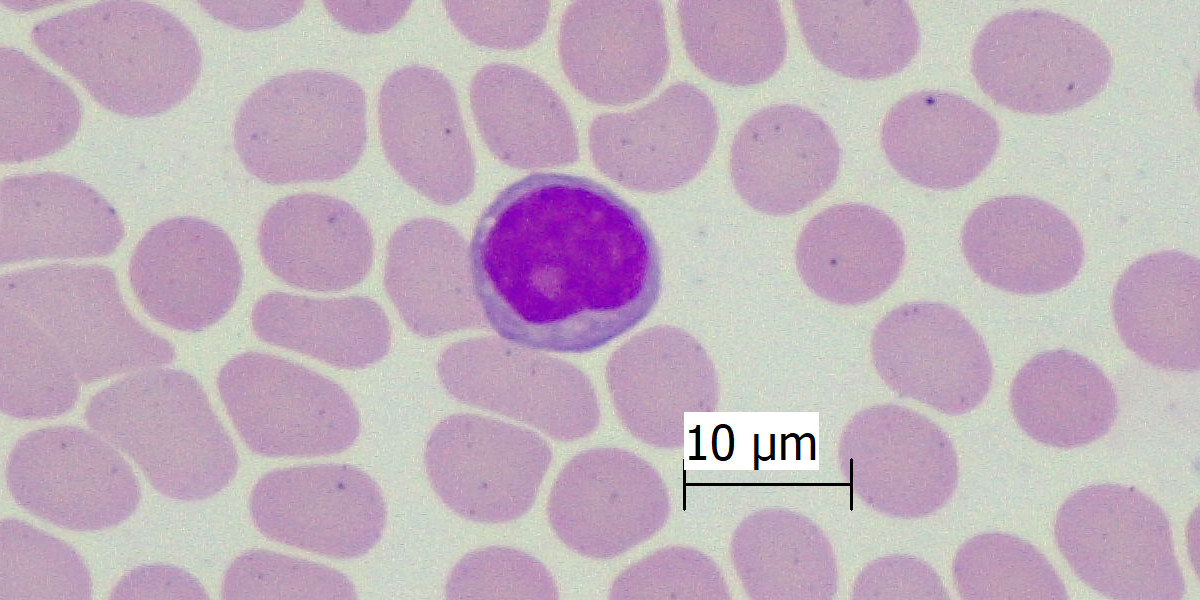

Eritrocito
Los eritrocitos o glóbulos rojos representan el principal elemento forme de la sangre. Su diámetro es de 7.8 μm. Se caracterizan por ser anucleados y tener una forma de disco bicóncavo. Esta estructura le confiere una tinción acidófila en la periferia y pálida en el centro.